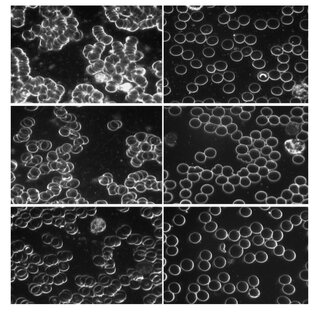

- Sinds 2012
- Best verkrijgbare kwaliteit wereldwijd
- Distributeur van Earthing.com in Nederland en België
- Enige aanbieder met garantie op de werking
AARDEN - VERBETERT DE DOORSTROMING VAN HET BLOED
- GAAT HET KLONTEREN VAN BLOED TEGEN
- HELPT HOGE BLOEDDRUK VERLAGEN*
Hartkloppingen, pijn op de borst, kortademig, hoesten, misselijkheid, pijn in de buik en overgeven, zwelling bij de enkel, pols of scheenbeen, pijnscheuten in de armen of benen kunnen duiden op bloedproppen die de bloedsomloop verstoren.
Aarden zorgt ervoor dat de elektrische spanning van de rode bloedlichaampjes normaliseert. Vergelijk het met magneten: de noordpolen van twee magneten stoten elkaar af en kunnen niet tegen elkaar aangeduwd worden.
Het oppervlak van rode bloedcellen draagt een negatieve elektrische lading die de afstand tussen de cellen in de bloedbaan in stand houdt. Hoe sterker de negatieve lading, hoe groter het potentieel van de cellen om elkaar af te stoten, hoe beter de viscositeit (dunner!) van het bloed en hoe beter de doorstroming. Dit potentieel wordt het zetapotentiaal genoemd.
AARDEN, HET EXPERIMENT MBT DE BLOEDSOMLOOP
Op de foto zie je wat het effect van aarden is op het zetapotentiaal van rode bloedcellen, afgenomen bij een van de tien deelnemers aan een experiment dat in 2013 werd gepubliceerd. De deelnemers werden gedurende twee uur geaard door middel van aardingspatches (elektroden ), geplaatst op de onderkant van beide voeten en de handpalmen, en met een draad verbonden met een grondpin die buiten in de grond is geplaatst.
Bij het experiment werd voor en aan het einde van de aardingssessie van elke deelnemer een enkele druppel bloed afgenomen.
Links zie je de aggregatie van rode bloedcellen (klontering) vóór het aarden.
Rechts zie je dat de aggregatie sterk verminderde na de aardingssessie: het verbeterde zetapotentiaal ofwel de aggregatie van rode bloedcellen (minder klontering) en betere doorstroming van rode bloedcellen.
AARDEN OPTIMALISEERT DE ELEKTRISCHE SPANNING VAN DE RODE BLOEDCELLEN
De verandering duidt op een grotere negatieve oppervlaktelading op de rode bloedcellen, als gevolg van het aarden, dat een sterker zetapotentiaal en een bloed’verdunnende’ werking heeft.
Met aarden optimaliseert de elektrische spanning van de rode bloedcellen en stroomt het bloed soepeler door de aderen.
Een dikkere bloedviscositeit wordt in verband gebracht met een aantal medische situaties, waaronder hoge bloeddruk, cholesterol, versnelde veroudering en diabetes mellitus.
*Slik je medicatie om je bloed beter te laten stromen en bloedproppen tegen te gaan en ga je starten met aarden, dan adviseren we in contact te zijn met de arts of specialist die de medicatie voorschrijft.